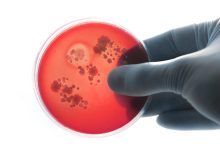

Labtv.net è un prodotto Consulservice S.r.l.
Labtv.net è il sito ufficiale del canale televisivo di Lab Tv canale 84 del digitale
terrestre Regione Campania
Sede legale: Via Chiaio, 5 –
83010 – Torrioni (AV)
P.IVA 02757950643 iscr. R.E.A. AV N.181151
Editore: Consulservice S.r.l.
Testata giornalistica Reg. Trib. di Benevento
n. 244 del 26.02.2015
Direttore Responsabile Dott.ssa Oliviero Antonella
Contatti: 0824.337274 – 327.7390733
redazione@labtv.net
Contattaci per la tua Pubblicità:
0824.337274 – 327.7390733
email: commerciale@labtv.net